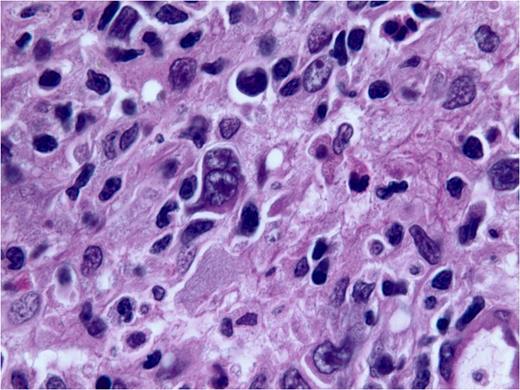
Figure.

Abstract
Abstract
Background: Hemophagocytic lymphohistiocytosis (HLH) is a syndrome of dysregulated immune activation with hypercytokininemia and macrophage activation that can manifest as pancytopenia, coagulopathy, usually progressing to multi-organ failure and death.
Case: We report a case of Hodgkin's lymphoma (HL) associated hemophagocytic lymphohistiocytosis with coexistent HIV and EBV viremia, where all four were diagnosed simultaneously. The patient presented with multi-organ failure but significant improvement was noted in HLH as soon as the ABVD regimen for the lymphoma was initiated; with patient ultimately discharged home.
Conclusion: HLH is a syndrome known to have high mortality. Prognosis can markedly improve with prompt initiation of appropriate treatment, therefore it is imperative to diagnose and begin therapy early. Usual presentation includes nonspecific symptoms and overlaps with many other diagnoses and can easily be overlooked. Therefore diagnostic criteria need to be refined and newer treatment options should be explored.
ABVD: Doxorubicin, Bleomycin, Vincristine and Dacarbazine
No relevant conflicts of interest to declare.
Author notes
Asterisk with author names denotes non-ASH members.
This feature is available to Subscribers Only
Sign In or Create an Account Close Modal